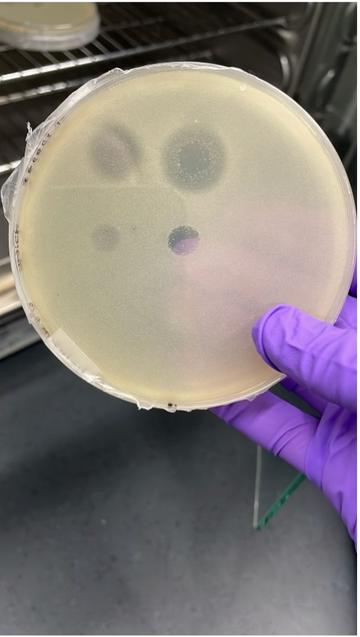

Archaea can kill bacteria with new antibacterials
A first look into the molecular defenses of archaea highlights the importance of surveying diverse microbes to discover new types of antimicrobials
The salt-loving Halalkalibacterium halodurans, growing on a petri dish in the Warnecke lab, is killed by proteins secreted by the archaeon Halogranum salarium
Aida Sanchez-Ricol (Warnecke lab) (CC-BY 4.0, https://creativecommons.org/licenses/by/4.0/)
As bacteria become increasingly resistant to antibiotics and other antibacterials, there is a growing need for alternatives. In a study published on 14 August 2025 in the open-access journal PLOS Biology, Tobias Warnecke and colleagues from the Department of Biochemistry at the University of Oxford and the MRC Laboratory of Medical Sciences, United Kingdom, identified untapped antimicrobials produced by archaea, single-celled organisms that make up one of the three domains of life (the other two being bacteria and eukaryotes, the group that includes us).
Microbes are in constant competition for space and resources and have developed various chemical weapons to fend off other microbial species. All of our antibiotics originally came from these defense systems, though historically, researchers have only investigated the arsenals of bacteria and fungi. There are over 20,000 species of archaea, and these cells often live surrounded by even more numerous bacterial species. The researchers predicted that to survive, the archaeal cells must have ways to compete with the bacteria, representing an unexplored trove of antimicrobials.
The researchers surveyed the genomes of over 3,700 species of archaea, looking for genes encoding proteins that could possibly be wielded against bacteria. They focused specifically on proteins that can cut the molecule peptidoglycan, an essential part of the cell walls of bacteria. The large majority of archaea don’t have peptidoglycan, so these proteins would only be necessary for microbial warfare.
These proteins were present among 5% of the archaeal species surveyed, with some species having multiple types. In the lab, the researchers tested the efficacy of some of the proteins and found that they successfully killed bacteria. They also studied the proteins’ structures, which indicated many were deployed outside of the cell, and some archaea even had components for an injection system that might directly deliver the deadly proteins to competing bacteria.
Much still remains to be discovered on how these molecular weapons may be used in the wild. The peptidoglycan-cutting proteins also represent only one type of antibacterial among many others that may be present among diverse species of archaea.
Warnecke notes: “Archaea are their own Domain of Life, different from bacteria, and different from eukaryotes (humans, plants, flies, etc.). We know very little about their social lives, including how they interact with their ubiquitous brethren – bacteria.”
Warnecke adds: “Our work sheds new light on the social lives or archaea and has implications for how we understand microbial communities. It also suggests that archaea might be a large, untapped reservoir for discovering novel antimicrobials in the future.”
Romain Strock, first author from the MRC Laboratory of Medical Sciences, adds: “Archaea are often depicted as either lone extremophiles or syntrophic partners. Our research depicts another, darker side to their social life.”
Read the paper in PLOS Biology: https://plos.io/3HEwdeL




